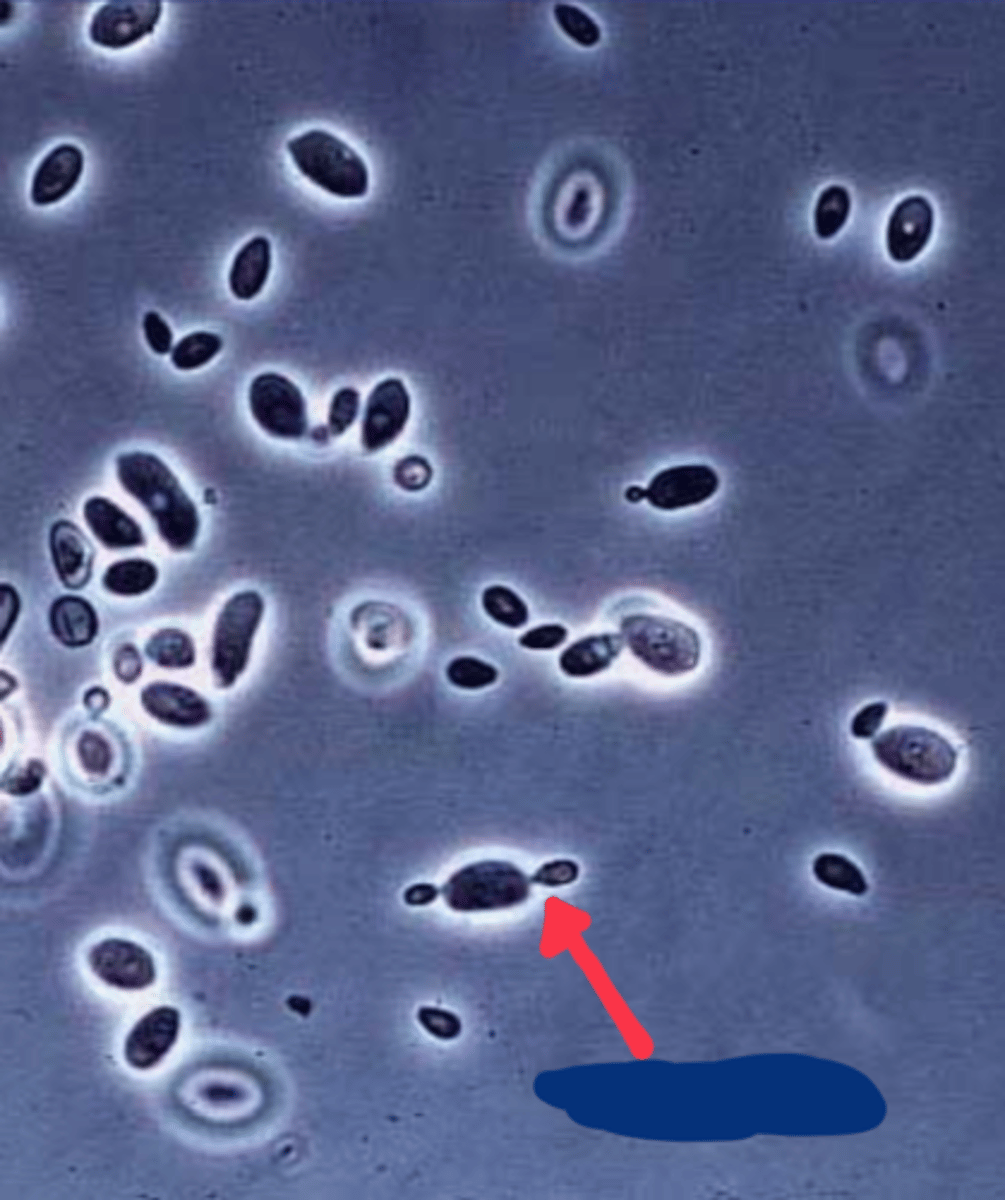
<p>yeast</p>

BIOSC 131 LAB EXAM 3
1/251
There's no tags or description
Looks like no tags are added yet.
Name | Mastery | Learn | Test | Matching | Spaced | Call with Kai |
|---|
No analytics yet
Send a link to your students to track their progress
252 Terms
plasmogamy
A

heterokaryotic stage
B

Karyogamy
C
The coming together and fusing of cell nuclei, as in fertilization.

Mycelium
D

Chytridiomycota
phylum?

Allomyces
Name?

male gametophyte
A

female gametophyte
B

Glomeromycota
phylum?
Zygomycota
phylum?

Rhizopus
Name?

Phycomyces
Name?

Pilobolus
Name?

Rhizopus Progametangia

Rhizopus gametangia and suspenders

n + n
ploidity

2n
ploidity

Rhizopus mature zygosporangium

sporangiophore
A
Asexual reproductive structure in Zygomycetes.

sporangia
B
Asexual reproductive structure in Zygomycetes.

zygosporangia

meiosporangium
What is this?

Haustoria
Glomeromycota, specialized parasitic hyphae that invade living cells and secrete digestive enzymes

vesicular-arbuscular mycorrhizae
Glomeromycota, endomycorrhizae that penetrate cortex cells with arbuscular structures, hyphal net around protoplast of cell that increases the protoplast volume and size, have vesicles of spores, VAM

Ascomycota
phylum?
sac fungi

Peziza
name?

Morchella
name?

ascospores
the sac in ascomycetes in which the sexual spores are formed.

Apothecia
cup like fungus that has asci lining the upper surface; ascomycotina

Perithecia
flask-shaped fruiting structures containing asci with ascospores

Sordaria
Flask-shaped perithecium. Each Clump Is an ascus Each Containing 8 ascospores

Ascospores (endogenous meiospores) of sordaria

ostiole
A
An opening or pore in an ascocarp or a pycnidium

Perithecium
B

yeast
common name of unicellular fungi

Saccharomyces cerevisiae
scientific name of yeast

Ascospores in ascus
yeast

budding
yeast
conidia
asexual spores

Penicillium
name?

conidiophore
A

conidia
B

Aspergillus
Ascomycota

Ascomycota
Phylum

Powdery Mildew
Plant Rust

Basidiomycota
Phylum of club fungi, typical mushroom

pileus
A
cap of mushroom

stipe
B
the stalk of a mushroom

gills
C

basidiospores
A

gill
B

Lichens
small plants that consist of algae (phycobiont) and fungi (mycobiont)

Crutose
crust like lichen

Foliose
leaf-like lichen

Fructose
upright growing lichen

Porifera
the phylum of sponges

mesohyl
A

Epidermis
B

Porocytes
C

Spongocoel
D

osculum
E

Chanocytes
F

Spicules
G

Amoebocytes
H

ostium
A

Spicules
B

Porocytes
C

incurrent canal
D

prosopyles
E & F

amebocyte
G

mesohyl
H

Apopyle
I

Choanocytes
J

Pinacocytes
K

radial canal
L

Scypha
name?

incurrent canal
A

radial canal
B

Spongocoel
C

Spongocoel
A

Apopyle
B

radial canal
C

incurrent canal
D

ostium
E

osculum
A

Spongocoel
B

Spicules
What is this?

Triaxon
A

monaxon
B

Sponge gemmule

Cnidaria
Phylum of jellyfish; corals; hydra, Simple nervous net and contractile cells

Nematocysts
A
specialized organelles within cnidocytes that eject a stinging thread

Hydrozoa
Class?

Cnidocytes
B
stinging cells

Hydra sp.
What is this genus? Class Hydrozoa

tentacle
A

gastrovascular cavity
C

Epidermis
D

Mesoglea
E
